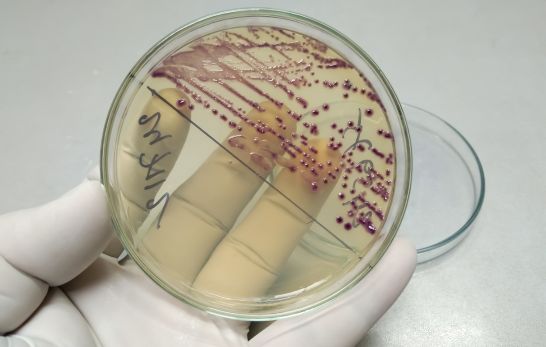

Gesundheitsanalysen sind ein wesentlicher Bestandteil der medizinischen Diagnostik und Prävention. Insbesondere bei der Untersuchung von Harnwegsinfektionen und anderen Nierenproblemen sind Urintests ein unverzichtbares Werkzeug. Dabei wird häufig zwischen zwei grundlegenden Untersuchungsmethoden unterschieden: der Urinkontrolle und der Harnkultur. Beide Methoden haben spezifische Ziele und bieten unterschiedliche Informationen über den Gesundheitszustand des Patienten. In diesem Artikel beleuchten wir die Unterschiede, Anwendungsbereiche und Bedeutungen von Urinkontrolle und Harnkultur.
Urinkontrolle: Schnell und spezifisch
Die Urinkontrolle, oft auch als Urinanalyse bezeichnet, ist ein grundlegender Test, der schnell Informationen über verschiedene Bestandteile des Urins liefert. Dieser Test umfasst normalerweise mehrere Abschnitte:
- Physikalische Untersuchung: Dabei werden Farbe, Klarheit und Konzentration des Urins beurteilt. Auffälligkeiten wie eine ungewöhnliche Farbe oder Trübheit können auf verschiedene Gesundheitsprobleme hinweisen.
- Chemische Analyse: Mithilfe von Teststreifen können verschiedene chemische Bestandteile im Urin analysiert werden, darunter Proteine, Glukose, Ketone, Bilirubin und der pH-Wert. Diese Bestandteile geben Auskunft über den Stoffwechsel und mögliche Erkrankungen wie Diabetes oder Leberprobleme.
- Mikroskopische Untersuchung: Im Rahmen dieser Untersuchung wird der Urin unter einem Mikroskop betrachtet, um Zellen, Kristalle, Bakterien und andere Mikropartikel zu identifizieren. Diese mikroskopischen Elemente können auf Infektionen oder andere Nierenschädigungen hinweisen.
Die Urinkontrolle ist ein schneller und nicht-invasiver Test, der in der ärztlichen Praxis oder im Labor vor Ort durchgeführt werden kann. Sie bietet einen sofortigen Überblick über mögliche Auffälligkeiten und ist daher ein sehr nützliches Werkzeug für die erste Diagnose.
Harnkultur: Präzise Erregeridentifikation
Während die Urinkontrolle allgemeine Informationen über den Zustand des Harns liefert, geht die Harnkultur einen Schritt weiter und untersucht spezifisch das Vorhandensein von Mikroorganismen. Die Harnkultur, auch als Urin-Kultur oder Urinbakterienkultur bekannt, dienen der Identifikation und Quantifizierung von Bakterien oder Pilzen, die eine Infektion verursachen könnten.
Bei der Harnkultur wird eine Urinprobe auf einem Nährmedium ausgebracht und für eine festgelegte Zeit inkubiert. Durch diese Methode können Mikroorganismen wachsen und kolonienbildende Einheiten (KBE) entwickeln. Folgende Schritte werden hierbei durchgeführt:
- Probenentnahme: Die Urinprobe wird steril entnommen, um Kontaminierung zu vermeiden. Dies ist wesentlich, um sicherzustellen, dass nur die wirklich im Urin vorhandenen Erreger nachgewiesen werden.
- Inkubation: Die Probe wird auf unterschiedliche Nährmedien übertragen und in einem Brutschrank bei Körpertemperatur inkubiert. Dies geschieht meist über einen Zeitraum von 24 bis 48 Stunden.
- Auswertung: Nach der Inkubationszeit werden die entstandenen Bakterienkolonien gezählt und mikrobiologisch analysiert. Dies erlaubt nicht nur die Identifizierung der vorhandenen Bakterienart, sondern auch deren Menge und damit die Beurteilung einer möglichen Infektion.
Die Harnkultur ist besonders dann wichtig, wenn spezifische Erreger identifiziert werden müssen, um eine gezielte antibiotische Behandlung einzuleiten. Zudem kann eine Empfindlichkeitsprüfung (Antibiogramm) durchgeführt werden, um die optimale medikamentöse Therapie zu bestimmen.
Anwendung und Bedeutung
Beide Untersuchungsmethoden spielen eine entscheidende Rolle in der medizinischen Diagnostik und haben jeweils ihre spezifischen Anwendungsmöglichkeiten:
- Urinkontrolle: Ideal für die schnelle Beurteilung des allgemeinen Gesundheitszustandes und zur Auffindung erster Anzeichen von Nierenproblemen, Harnwegsinfektionen, Diabetes und anderen Stoffwechselstörungen. Sie ist oft der erste Schritt bei der Diagnose.
- Harnkultur: Unverzichtbar bei Verdacht auf bakterielle oder pilzliche Harnwegsinfektionen. Sie ermöglicht eine exakte Identifikation der Erreger und die Bestimmung des geeignetsten Antibiotikums, was besonders bei rezidivierenden oder komplizierten Infektionen von Bedeutung ist.
Zusammenfassend lässt sich sagen, dass sowohl die Urinkontrolle als auch die Harnkultur wesentliche Werkzeuge in der Medizin sind. Die Urinkontrolle liefert schnelle und grundlegende Informationen über den allgemeinen Gesundheitszustand, während die Harnkultur eine detaillierte Analyse von Erregern ermöglicht, was für die gezielte Behandlung von Infektionen entscheidend ist. Das Verständnis und die richtige Anwendung beider Methoden tragen maßgeblich zur effektiven Diagnostik und Therapie von Harnwegserkrankungen bei.